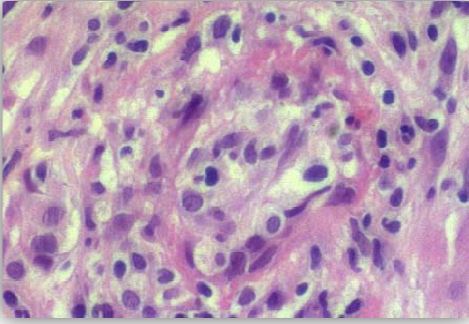

النبات

مواضيع عامة في علم النبات

الجذور - السيقان - الأوراق

النباتات الوعائية واللاوعائية

البذور (مغطاة البذور - عاريات البذور)

الطحالب

النباتات الطبية


الحيوان

مواضيع عامة في علم الحيوان

علم التشريح

التنوع الإحيائي

البايلوجيا الخلوية


الأحياء المجهرية

البكتيريا

الفطريات

الطفيليات

الفايروسات


علم الأمراض

الاورام

الامراض الوراثية

الامراض المناعية

الامراض المدارية

اضطرابات الدورة الدموية

مواضيع عامة في علم الامراض

الحشرات


التقانة الإحيائية

مواضيع عامة في التقانة الإحيائية


التقنية الحيوية المكروبية

التقنية الحيوية والميكروبات

الفعاليات الحيوية

وراثة الاحياء المجهرية

تصنيف الاحياء المجهرية

الاحياء المجهرية في الطبيعة

أيض الاجهاد

التقنية الحيوية والبيئة

التقنية الحيوية والطب

التقنية الحيوية والزراعة

التقنية الحيوية والصناعة

التقنية الحيوية والطاقة

البحار والطحالب الصغيرة

عزل البروتين

هندسة الجينات


التقنية الحياتية النانوية

مفاهيم التقنية الحيوية النانوية

التراكيب النانوية والمجاهر المستخدمة في رؤيتها

تصنيع وتخليق المواد النانوية

تطبيقات التقنية النانوية والحيوية النانوية

الرقائق والمتحسسات الحيوية

المصفوفات المجهرية وحاسوب الدنا

اللقاحات

البيئة والتلوث


علم الأجنة

اعضاء التكاثر وتشكل الاعراس

الاخصاب

التشطر

العصيبة وتشكل الجسيدات

تشكل اللواحق الجنينية

تكون المعيدة وظهور الطبقات الجنينية

مقدمة لعلم الاجنة


الأحياء الجزيئي

مواضيع عامة في الاحياء الجزيئي


علم وظائف الأعضاء


الغدد

مواضيع عامة في الغدد

الغدد الصم و هرموناتها

الجسم تحت السريري

الغدة النخامية

الغدة الكظرية

الغدة التناسلية

الغدة الدرقية والجار الدرقية

الغدة البنكرياسية

الغدة الصنوبرية

مواضيع عامة في علم وظائف الاعضاء

الخلية الحيوانية

الجهاز العصبي

أعضاء الحس

الجهاز العضلي

السوائل الجسمية

الجهاز الدوري والليمف

الجهاز التنفسي

الجهاز الهضمي

الجهاز البولي


المضادات الميكروبية

مواضيع عامة في المضادات الميكروبية

مضادات البكتيريا

مضادات الفطريات

مضادات الطفيليات

مضادات الفايروسات

علم الخلية

الوراثة

الأحياء العامة

المناعة

التحليلات المرضية

الكيمياء الحيوية

مواضيع متنوعة أخرى

الانزيمات
الجنس Coxiella burnetii
المؤلف:
عبد الرزاق سليمان التومي ، محمد محمد الامام ، عبد الباسط رمضان
المصدر:
اساسيات التشخيص البكتريولوجي المعملي والسريري
الجزء والصفحة:
18-7-2016
2226
Coxiella burnetii
يصنف هذا النوع البكتيري ضمن عائلة Coxelliacaea وهو عبارة عن خلايا كروي الشكل أو عصويات قصيرة وهي تتكاثر داخل خلايا العائل ، وتفاعلها مع صبغة جرام غير جيد ويستحن صبغها باستعمال صبغة Giemsa .
خزعة الكبد وهي تحتوي على النوع البكتيري Coxiella burnetii
الامراضية :
يشبه هذا النوع البكتيري إلى حد كبير الجنس البكتيري Rickettsiae إلا أنه لا ينتقل بواسطة الحشرات ومن الممكن انتقاله من خلال الحبل السري من الأم إلى الجنين أو بواسطة الغبار أو البراز أو من خلال تناول الحليب الملوث، وهو له القدرة على مقاومة الجفاف والحرارة وكذلك أشعة الشمس، ويصيب هذا النوع البكتيري الرئتين مع عدم ظهور أي طفح جلدي، وهو مرض ينتقل من الحيوان إلى الإنسان zoonotic disease حيث يعتبر الماعز والخراف والأبقار والقوارض والثدييات البرية وعدة أنواع من الطيور المخزن الطبيعي لهذا النوع البكتيري ، ويصيب في الغالب المزارعين والعاملين في السلخانات والبياطرة وكل من يتعامل مع الحيوانات التي قد تكون مصابة، فور استنشاق خلايا هذا النوع البكتيري فإنها تبدأ على الفور في التضاعف داخل الحويصلات وبعد ثلاثة أسابيع من الحضانة تظهر على المريض أعراض الصداع الحاد وأعراض تنفسية والتهاب رئوي غير نمطي ومن المحتمل الإصابة بالتهاب الكبد وهو ما يعرف بداء حمى الاستفهام Q fever (query) وقد تختفي هذه الأعراض في غضون اسبوعين او تستمر لتصبح الإصابة مزمنة. تصيب خلايا هذا النوع البكتيري بصورة خاصة الطحال والكبد مما يؤدي لتضخم هذه الأعضاء ، وتشبه الأعراض المرضية في هذه الإصابة تلك التي تظهر جراء الإصابة بالإنفلونزا حيث تظهر على المريض أعراض الحمى والصداع الشديدين مع الشعور بالإرهاق وألم بكامل الجسم ، ومن المضاعفات الخطرة التي قد تلي الإصابة بداء Q fever الإلتهاب الرئوي والتهاب بطانة القلب المزمن وإصابات الكبد. ويعتبر المضاد الحيوي Tetracycline لمدة 2-1 يوم العلاج الفعال لهذه الحالة المرضية حيث يساعد على تخفيض درجة الحرارة والتخلص من الحمى وفي حالات الإصابة بإلتهاب طانة القلب قد يستلزم الأمر تركيب صمام جديد.
التشخيص المعملي :
يمكن الاعتماد على الاختبارات المصلية لتشخيص الحالات المصابة بداء Q fever بحيث يتم الكشف على الارتفاع في معدل complement fixation titer (CFT) لأربع أضعاف. ويمر هذا النوع البكتيري خلال الإصابة بطورين من المستضدات يعرفان بالطور الأول phase 1 والطور الثاني phase 2 وتظهر الأجسام المضادة لمستضد الطور الاول فقط في احلات الإصابة المزمنة ، بينما تظهر الأجسام المضادة لمستضدات الطور الثاني فقط خلال الإصابة الحادة كما يعتبر اختبار indirect microimmunofluorescence test (IMIF) اكثر حساسية من اختبار CFT وذلك في المراحل الأولى من الإصابة كما يمكن تحديد وجود خلايا النوع البكتيري C. burnetii في المزارع الخليوية cell cultures ، وبيض الدجاج embryonated hen eggs أو حيوانات التجارب إلا أن نتائجها غير موثوق فيها. كما يمكن استعمال تقنية التفاعل المتسلسل للبوليمرات PCR للتعرف على تسلسل الحمض النووي (الدنا) للبكتيريا الممرضة إلا ان طريقة الكشف على الأجسام المضادة هي الأكثر استعمالاً.
 الاكثر قراءة في البكتيريا
الاكثر قراءة في البكتيريا
 اخر الاخبار
اخر الاخبار
اخبار العتبة العباسية المقدسة

الآخبار الصحية















 قسم الشؤون الفكرية يصدر كتاباً يوثق تاريخ السدانة في العتبة العباسية المقدسة
قسم الشؤون الفكرية يصدر كتاباً يوثق تاريخ السدانة في العتبة العباسية المقدسة "المهمة".. إصدار قصصي يوثّق القصص الفائزة في مسابقة فتوى الدفاع المقدسة للقصة القصيرة
"المهمة".. إصدار قصصي يوثّق القصص الفائزة في مسابقة فتوى الدفاع المقدسة للقصة القصيرة (نوافذ).. إصدار أدبي يوثق القصص الفائزة في مسابقة الإمام العسكري (عليه السلام)
(نوافذ).. إصدار أدبي يوثق القصص الفائزة في مسابقة الإمام العسكري (عليه السلام)


















